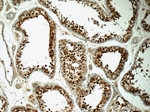
CSE1L Antibody in Immunohistochemistry (Paraffin) (IHC (P))

Search
Proteintech
CSE1L Polyclonal Antibody
{{$productOrderCtrl.translations['antibody.pdp.commerceCard.promotion.promotions']}}
{{$productOrderCtrl.translations['antibody.pdp.commerceCard.promotion.viewpromo']}}
{{$productOrderCtrl.translations['antibody.pdp.commerceCard.promotion.promocode']}}: {{promo.promoCode}} {{promo.promoTitle}} {{promo.promoDescription}}. {{$productOrderCtrl.translations['antibody.pdp.commerceCard.promotion.learnmore']}}
产品信息
22219-1-AP
种属反应
已发表种属
宿主/亚型
分类
类型
抗原
偶联物
形式
浓度
规格
纯化类型
保存液
内含物
保存条件
运输条件
产品详细信息
Immunogen sequence: RITCKANPA AVVNFEEALF LVFTEILQND VQEFIPYVFQ VMSLLLETHK NDIPSSYMAL FPHLLQPVLW ERTGNIPALV RLLQAFLERG SNTIASAAAD KIPGLLGVFQ KLIASKANDH QGFYLLNSII EHMPPESVDQ YRKQIFILLF QRLQNSKTTK FIKSFLVFIN LYCIKYGALA LQEIFDGIQP KMFGMVLEKI IIPEIQKVSG NVEKKICAVG ITKLLTECPP MMDTEYTKLW TPLLQSLIGL FELPEDDTIP DEEHFIDIED TPGYQTAFSQ LAFAGKKEHD PVGQMVNNPK IHLAQSLHKL STACPGRVPS MVSTSLNAEA LQYLQGYLQA ASVTLL (627-971 aa encoded by BC109313)
靶标信息
Proteins that carry a nuclear localization signal (NLS) are transported into the nucleus by the importin-alpha/beta heterodimer. Importin-alpha binds the NLS, while importin-beta mediates translocation through the nuclear pore complex. After translocation, RanGTP binds importin-beta and displaces importin-alpha. Importin-alpha must then be returned to the cytoplasm, leaving the NLS protein behind. The protein encoded by this gene binds strongly to NLS-free importin-alpha, and this binding is released in the cytoplasm by the combined action of RANBP1 and RANGAP1. In addition, the encoded protein may play a role both in apoptosis and in cell proliferation.
仅用于科研。不用于诊断过程。未经明确授权不得转售。
生物信息学
蛋白别名: BCR/ABL fusion protein; BCR/ABL1 fusion; CAS; Cellular apoptosis susceptibility protein; Chromosome segregation 1-like protein; CSE1 chromosome segregation 1-like; epididymis secretory sperm binding protein; Exp2; Exportin-2; Importin-alpha re-exporter; MGC117283; MGC130036; MGC130037; putative Ran-binding domain; unnamed protein product
基因别名: 2610100P18Rik; AA407533; Capts; CAS; CSE1; CSE1L; XPO2
UniProt ID: (Human) P55060, (Mouse) Q9ERK4
Entrez Gene ID: (Human) 1434, (Mouse) 110750